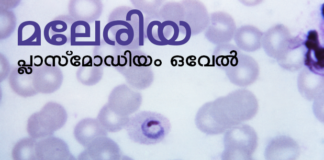
അപൂര്വ്വ മലേരിയ രോഗാണുവിനെ കേരളത്തില് ആദ്യമായി കണ്ടെത്തി

Tag: Maleria
അപൂര്വ്വ മലേരിയ രോഗാണുവിനെ കേരളത്തില് ആദ്യമായി കണ്ടെത്തി
കണ്ണൂര്: ഇന്ത്യയില് അപൂര്വ്വമായി കാണപ്പെടുന്ന പ്രത്യേക മലേറിയ രോഗാണുവിനെ കേരളത്തില് കണ്ടെത്തി. സുഡാനില് നിന്നും വന്ന കണ്ണൂര് സ്വദേശിയുടെ രക്തപരിശോധനയില് ആണ് ഇത് കണ്ടെത്തിയത്. കണ്ണൂര് ജില്ലാ ആശുപത്രിയില് നടത്തിയ പരിശോധനയിലാണ് ജില്ലാ...